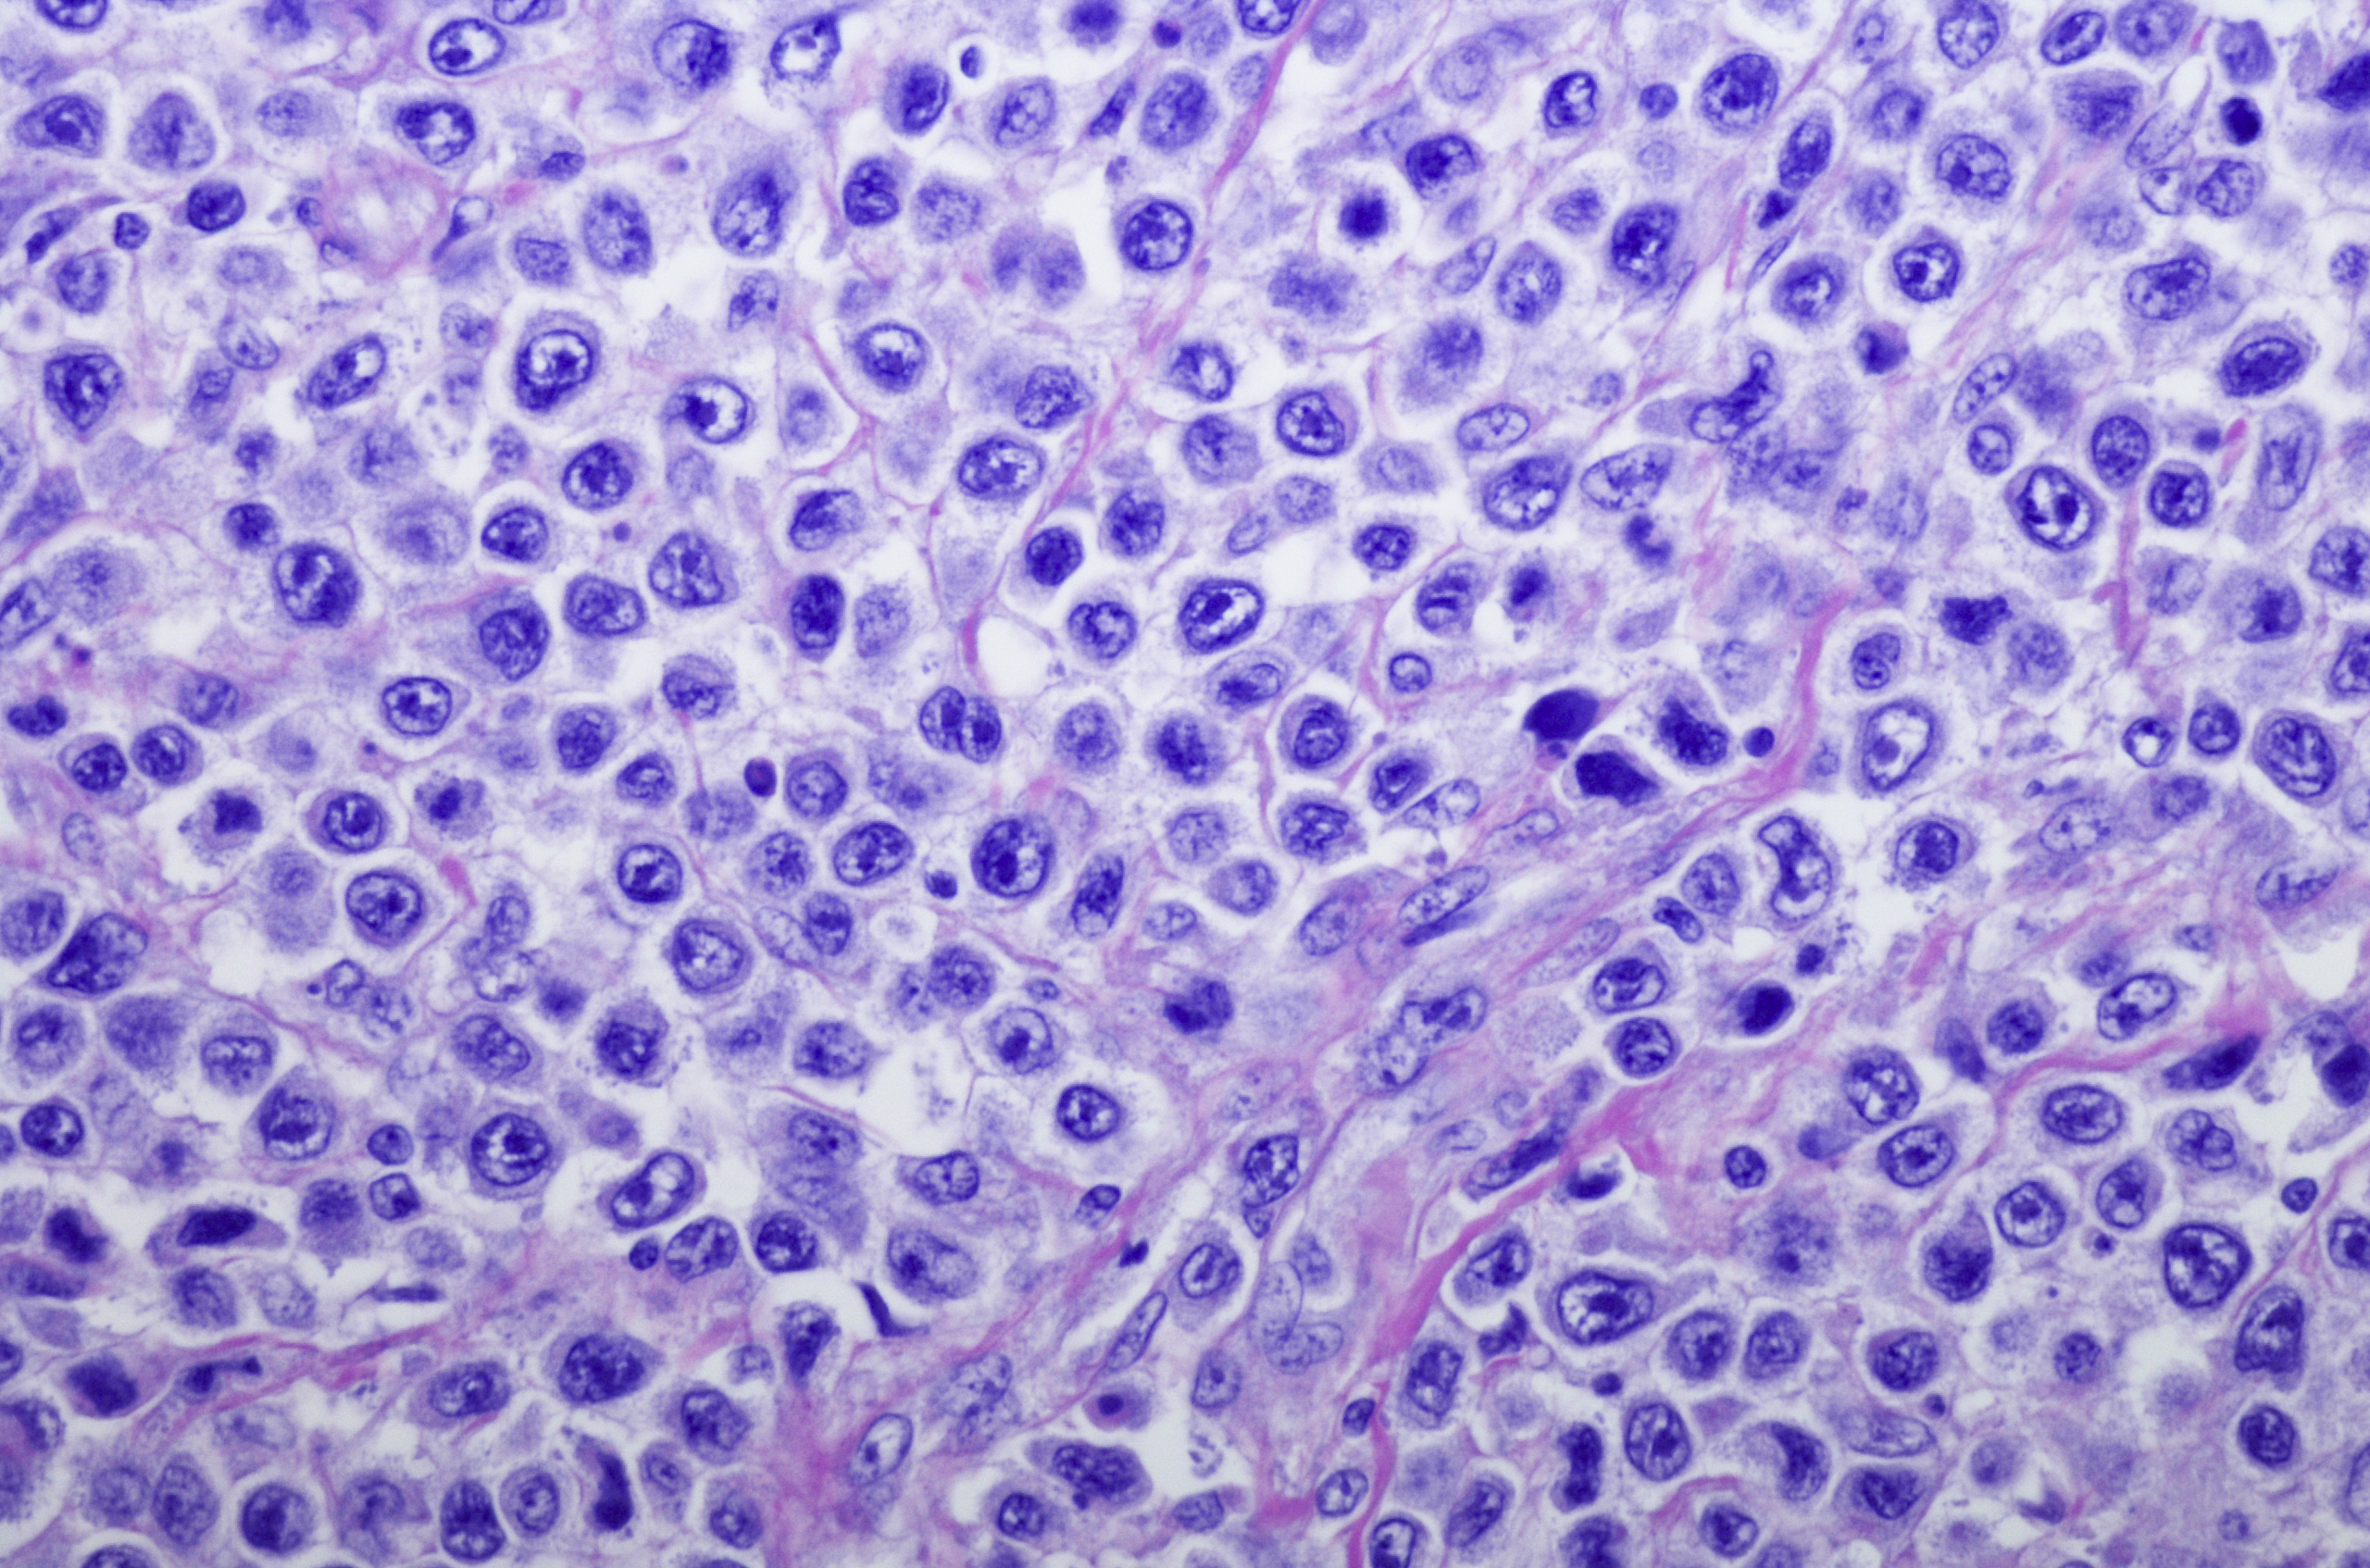

Lymphoma Cancer
Learn about lymphoma cancer
Lymphoma occurs when abnormal cells in the body’s lymphatic system grow in an uncontrolled way.
The lymphatic system is part of the immune system and is made up of:
- Lymphatic vessels: tiny vessels that collect waste products from the body’s tissues in fluid called lymph.
- Lymph: contains white blood cells including cells called lymphocytes. Lymphocytes help protect the body against infections.
- Lymph nodes: these store white blood cells and help to filter out waste products.
The immune system also includes tissues such as bone marrow, tonsils and the spleen.
Approximately 70–80% of lymphomas develop in the lymph nodes and the rest develop outside of the lymph nodes.
There are two main types of lymphoma:
Hodgkin Lymphoma
Non-Hodgkin Lymphoma
Symptoms most commonly associated with lymphoma include:
- Swollen lymph node glands typically located in the neck or above the collarbone, underarms or groin.
- Unexplained weight loss
- Unexplained fatigue
- Excessive sweating especially at night
- Itchy skin or itchy red lumps
- Fever
- Loss of appetite
- Frequent infections
- Unexplained cough or shortness of breath
- Unexplained headaches
- Bruising easily
- Swollen abdomen
Some of these symptoms can be caused by common illnesses and are not limited to lymphoma alone. Distinct forms of lymphoma can lead to varying symptoms and children may experience different symptoms to adults. Initially, Hodgkin’s Lymphoma may only produce mild symptoms, making it challenging to diagnose accurately.
Yes, Lymphoma is a type of blood cancer which develops in the white blood cells called lymphocytes.
The survival rate for patients diagnosed with lymphoma, over a five-year period, between 2014 – 2018 was 78% (76% for males and 79% for females).
Lymphoma has different types, and their treatments and prognoses vary. Non-Hodgkin Lymphoma that originates in B-cells has a higher likelihood of successful treatment compared to T-cell lymphomas which are generally more challenging to cure. However, even if it can’t be cured T-cell lymphoma can still be managed for many years with intermittent treatment. The specific follow-up care needed depends on the type of lymphoma.
At the end of 2017, 23,141 people were recorded living with lymphoma who were diagnosed in a 5 year period (2013 – 2017)
The likelihood of developing non-Hodgkin’s lymphoma is slightly increased if you have a close relative who has previously had the cancer also.
Larger B-cell lymphomas arise from B lymphocytes, the white bloods responsible to produce antibodies. 85% of all lymphoma cases in Australia are non-Hodgkin’s lymphoma.
There are a number of ways to diagnosis of lymphoma, including:
- Physical examination from healthcare professional
- Blood tests to check blood cell count along with any abnormalities in kidneys, liver or bone marrow.
- Biopsy from the lymph nodes, skin or bone marrow to be examined under a microscope
- A range of imaging testing such as CT scan, MRI scan or PET scan to detect cancer in the body.
- Extraction of spinal cord fluid, usually to check if lymphoma is located in the nervous system.
Lymphoma cancer affects the lymphatic system, which plays a crucial role in transporting immune cells throughout the body and eliminating waste products from these immune functions. The lymphatic system is composed of lymphatics vessels and lymph fluid.
Swollen lymph glands caused by lymphoma are often observed in the neck, groin, and armpit regions as they are closer to the surface of the skin and easier to locate. However, lymph nodes exist throughout the body and can become swollen anywhere. Although the cancer typically originates in the lymph nodes, it can also develop in other areas such as the skin, liver, brain, or spinal cord.
There are more than 80 distinct subtypes of lymphoma, some of which are more prevalent than others. Among these, over 75 subtypes are classified as non-Hodgkin’s lymphoma, while five subtypes are Hodgkin’s lymphoma.
Knowing the type of subtype lymphoma diagnosis is crucial in determining the appropriate treatment and understanding the progression of the cancer.


